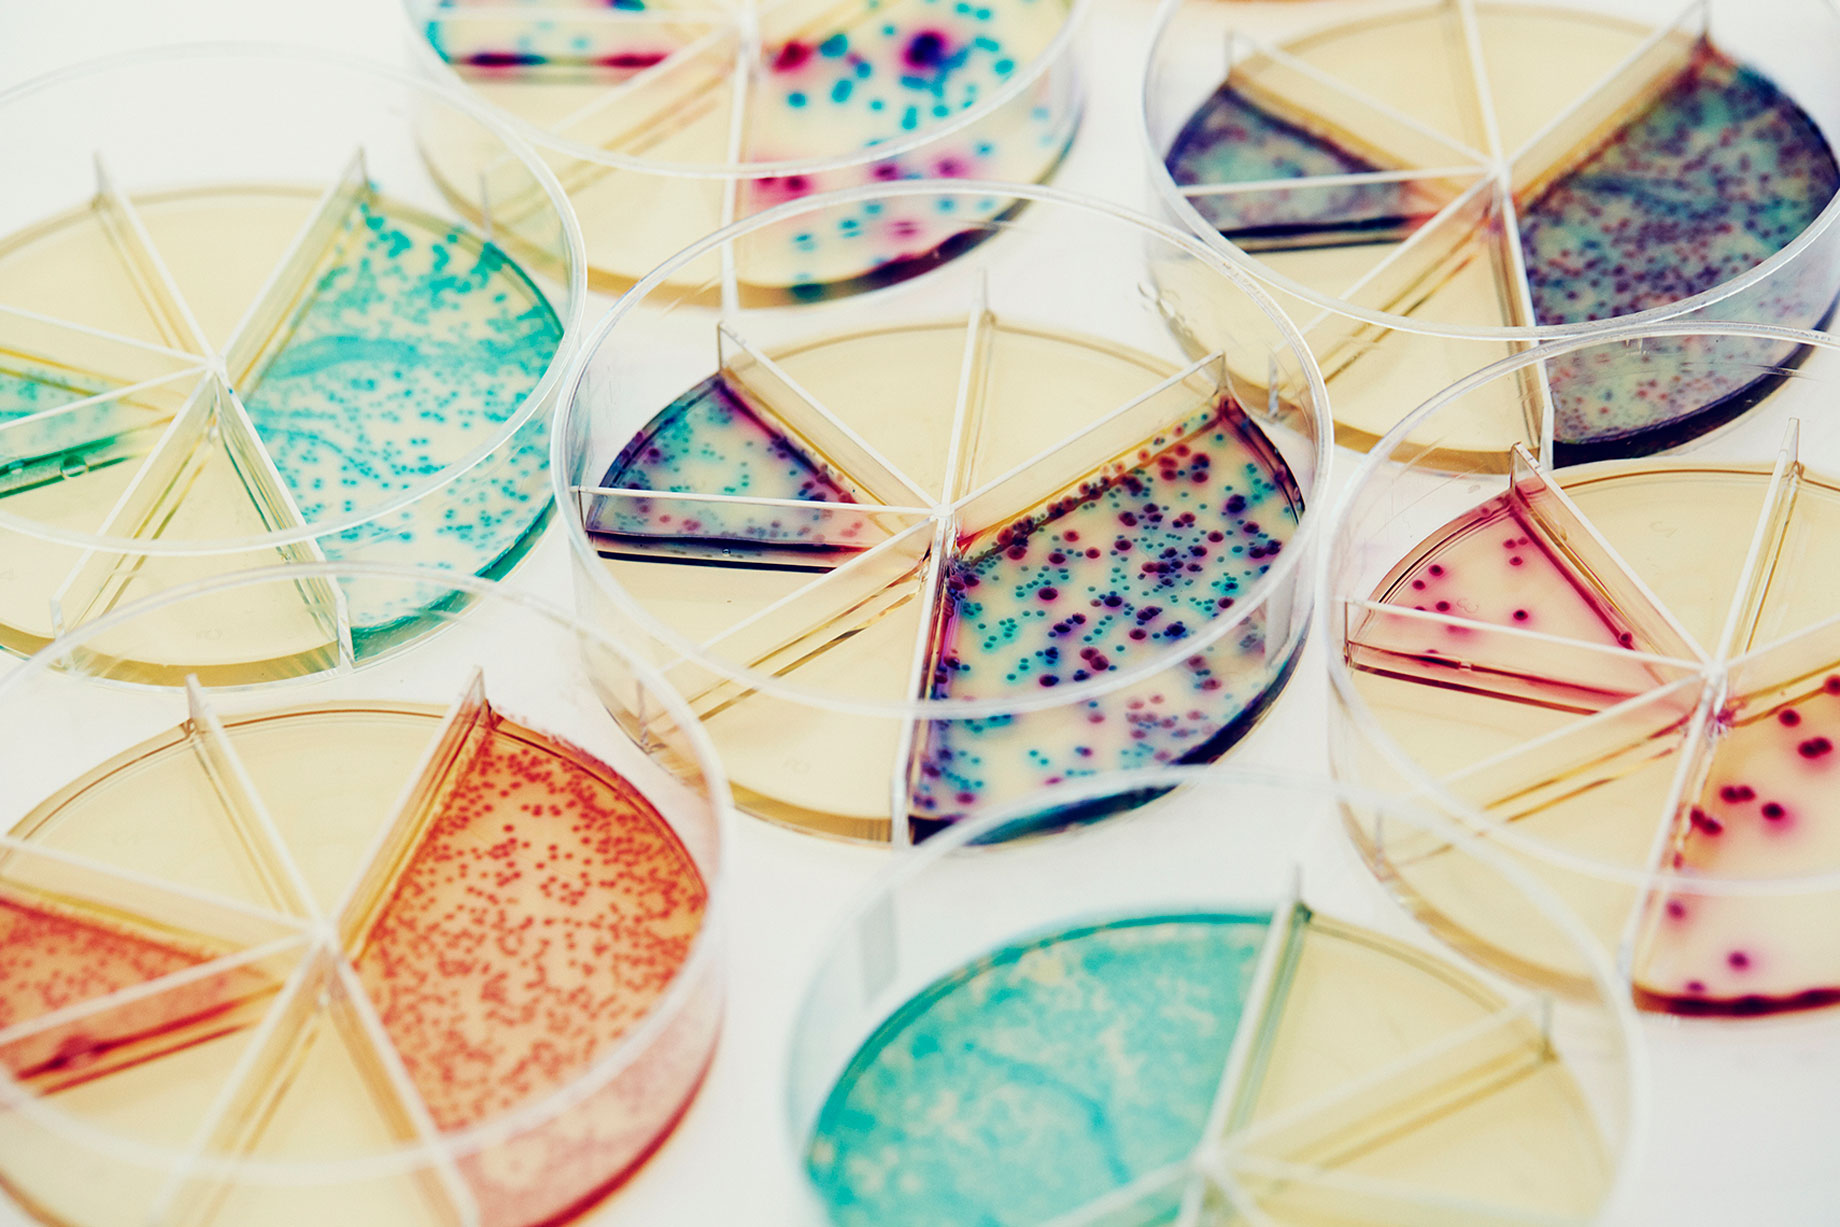

FORSIDE - STATENS SERUM INSTITUT
STATENS SERUM INSTITUT
by Tuala Hjarnø
STATENS SERUM INSTITUT - Slide 2
STATENS SERUM INSTITUT - Slide 3
STATENS SERUM INSTITUT - Slide 4
STATENS SERUM INSTITUT - Slide 5
STATENS SERUM INSTITUT - Slide 6
STATENS SERUM INSTITUT - Slide 7
STATENS SERUM INSTITUT - Slide 8
STATENS SERUM INSTITUT - Slide 9
STATENS SERUM INSTITUT - Slide 10
STATENS SERUM INSTITUT - Slide 11


















































































